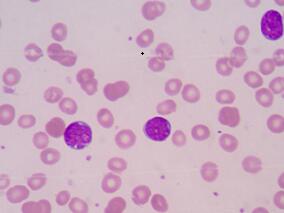
53岁男子乏力发热 输注“参麦”后全身水肿

-
28岁小伙2年来头痛恶心当“感冒”治 到头来发现“大…
环球医学资讯
2019年04月22日
点击量:261
1小时条评论28岁男性,2年前偶有头痛并伴有恶心、呕吐,都当作感冒治疗。4天前,患者无诱因再次出现头胀痛、恶心、呕吐,并自觉视力下降,偶有饮水呛咳,没想到罪魁祸首竟是颅内原发性恶性黑色素瘤。 病史:男性,28岁。头痛伴呕吐2年,加重4天。2年前患者偶有头痛,并伴有...
-
47岁男性反复腹胀伴黑便3个月 病因出乎意料
环球医学资讯
2019年04月15日
点击量:265
1小时条评论47岁男性,近3个月来,反复出现腹胀,进食后明显,伴黑便,当时未予任何诊治,近2周来,上述症状加重,逐渐出现乏力、食欲缺乏和体重下降,最后诊断竟是较为罕见的原发于消化道的恶性黑色素瘤。 【典型病例】 一般情况:患者谭times;,男,47岁,胃镜检查时间20...
-
54岁男性吸烟30年日均10支 被癌中之王盯上
环球医学资讯
2019年04月08日
点击量:281
1小时条评论54岁男性,半月前无明显诱因出现持续性头痛,伴恶心、呕吐,渐重。用脱水、止痛药可缓解,无发热、抽搐,无肢体活动障碍。既往健康,无黑痣手术史,吸烟30年日均10支,最后诊断竟为癌中之王,令人唏嘘...... 病历资料 患者男,54岁。半月前,无明显诱因出现持续...
-
58岁女性阴道出血淋漓不尽 多处散在点状黑色组织
环球医学资讯
2019年04月01日
点击量:445
1小时条评论阴道恶性黑色素瘤非常少见,大多数发生在阴道远端,多为深部浸润,易发生远处转移,预后不佳。阴道恶性黑色素瘤有哪些临床表现?如何治疗?请看以下病例: 牛XX,58岁,G4P1,自然绝经8年。 3+个月前无明显诱因出现阴道出血,血水样,初时量少,伴异味,并有下...
-
53岁男子乏力发热 输注“参麦”后全身水肿
环球医学资讯
2018年12月10日
点击量:232
1小时条评论53岁男患者,1月前无明显诱因下出现乏力,2周前乏力加重,自感发热,伴口唇疱疹,当地医院就诊。予输注 参麦后出现全身水肿,乏力、发热未有明显好转,查血常规示三系减少。患者最终综合形态学、免疫表型分型、融合基因等检查确诊,所患何病? 【简要病史】 患者,...
-
EGFR突变的晚期NSCLC 靶向药物如何使用威力最大?
环球医学资讯
2018年11月22日
点击量:710
1小时条评论【引言】晚期非小细胞肺癌(non-small-cell lung carcinoma,NSCLC)的治疗包括化疗和靶向治疗,其中靶向治疗已经成为研究的热点。已上市的EGFR-TKI可以在很大程度上改善EGFR基因突变患者的生存状态,作为目前最常使用的靶向治疗药,EGFR-TKI仍然显示着持久活力。针...
-
NSCLC姑息切除术后综合治疗模式了解一下
环球医学资讯
2018年11月20日
点击量:324
1小时条评论通过学习71岁男性非小细胞肺癌(NSCLC)术后(R2切除;T2N1M0)的病例,与您共同掌握NSCLC术后辅助化疗的指征、熟悉NSCLC综合治疗的模式,并了解NSCLC同步放化疗的原则。 病例介绍 主诉 左肺癌术后1月余,为行化疗入院。 现病史 患者于3个月前健康查体时发现左...
-
多发性骨髓瘤罕见并发症一例
环球医学资讯
2018年05月04日
点击量:722
1小时条评论【临床资料】 患者,男,37岁。主因活动后憋气1年余,鼻出血2月余。曾于2008年4月就诊于北京协和医院。该患者于2006年下半年开始于饮酒﹑感冒﹑劳累后出现胸闷﹑憋气,无心前区疼痛,无咳嗽﹑咳痰﹑无晕厥。且易感冒﹑发烧,经常出现口周疱疹。2007年下半年开始于晨...
-
患儿继发ANCA相关性小血管炎 元凶竟是一种药!
环球医学资讯
2017年12月22日
点击量:324
1小时条评论ANCA(抗中性粒细胞质抗体)相关性小血管炎是系统性血管炎分类中的一类。系统性血管炎是指血管壁的炎症和纤维素样坏死为病理特征的一组系统性疾病。血管炎可分为原发性和继发性,原发性是指目前病因不明者,继发性是指继发于感染、肿瘤、肝病、系统性红斑狼疮等。 ...
-
罕见的心脏嗜铬细胞瘤在诊治上有何特殊性?
环球医学资讯
2017年12月22日
点击量:1206
1小时条评论肾上腺外的嗜铬细胞瘤也称为副神经节瘤,多发于腹部。原发于心脏的嗜铬细胞瘤源于副神经节和内脏自主神经副神经节,最多见于左心房。由于肿瘤常累及瓣膜或冠状动脉血供,手术切除困难,预后一般较差。心脏嗜铬细胞瘤较少见,其临床表现有哪些?如何定位诊断和治疗?...

会员登录

